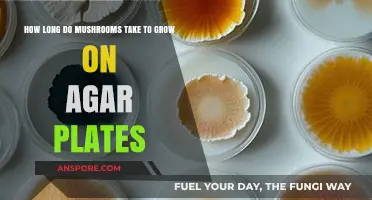
Growing Mushrooms on Agar: Understanding the Timeframe for Optimal Results

Oyster mushrooms are a popular choice for home growers and commercial cultivators alike due to their relatively quick growth cycle and high yield potential. On average, oyster mushrooms take about 2 to 4 weeks to grow from the time the mycelium is introduced to a suitable substrate, such as straw or sawdust, until the mushrooms are ready for harvest. The process begins with colonization, where the mycelium spreads through the substrate, which typically takes 1 to 2 weeks. Once colonization is complete, the mushrooms enter the fruiting stage, where they develop visible caps and stems, usually within 7 to 14 days, depending on environmental conditions like temperature, humidity, and light. Optimal growing conditions, such as maintaining a temperature range of 60–75°F (15–24°C) and high humidity, can significantly influence the speed and success of the growth cycle.
| Characteristics | Values |
|---|---|
| Spawn to Fruiting Time | 2-4 weeks after inoculation (depending on conditions) |
| Fruiting Period | 5-14 days for mushrooms to mature |
| Harvest Window | Multiple flushes possible (2-4 harvests), each lasting 5-7 days |
| Total Grow Cycle | 4-8 weeks from spawn inoculation to final harvest |
| Optimal Temperature Range | 60-75°F (15-24°C) |
| Humidity Requirement | 60-80% during fruiting |
| Substrate Colonization Time | 2-4 weeks (straw, sawdust, or coffee grounds) |
| Light Needs | Indirect light (not direct sunlight) |
| Common Substrates | Straw, sawdust, coffee grounds, paper products |
| pH Range for Substrate | 5.5-6.5 |
| Notable Factors Affecting Growth | Temperature, humidity, substrate quality, and air exchange |
| Yield per Pound of Substrate | 0.5-1.5 pounds (0.2-0.7 kg) of fresh mushrooms |
| Difficulty Level | Beginner-friendly |
| Common Varieties | Pearl oyster, blue oyster, golden oyster, phoenix oyster |
| Post-Harvest Storage | 5-7 days in refrigerator; best used fresh |
Explore related products
What You'll Learn
- Spawn to Fruiting: Time from spawn inoculation to first mushroom pins appearing
- Fruiting Duration: How long mushrooms take to grow from pins to harvestable size
- Environmental Factors: Impact of temperature, humidity, and light on growth speed
- Substrate Breakdown: Time needed for mycelium to colonize the growing substrate fully
- Harvest Cycles: Frequency and number of flushes possible per grow cycle

Spawn to Fruiting: Time from spawn inoculation to first mushroom pins appearing
The journey from spawn inoculation to the first mushroom pins appearing, known as the "spawn to fruiting" phase, is a critical period in oyster mushroom cultivation. This stage typically takes 2 to 4 weeks, depending on several factors such as temperature, humidity, substrate quality, and the specific strain of oyster mushroom being grown. After inoculating the substrate with spawn, the mycelium begins to colonize the material, breaking down nutrients and preparing for fruiting. During this time, maintaining optimal conditions is crucial to ensure healthy and timely growth.
Temperature plays a significant role in this phase, with the ideal range for oyster mushroom mycelium growth being 65°F to 75°F (18°C to 24°C). If temperatures are too low, colonization slows down, delaying the appearance of mushroom pins. Conversely, temperatures above 80°F (27°C) can stress the mycelium and inhibit fruiting. Humidity levels should also be closely monitored, as the substrate needs to remain moist but not waterlogged. Proper ventilation is essential to prevent contamination and ensure the mycelium thrives.
Once the substrate is fully colonized, the mycelium will begin to initiate fruiting. This transition is triggered by environmental changes, such as a drop in temperature, increased fresh air exchange, and light exposure. The first signs of fruiting, known as "pinning," appear as tiny knots or bumps on the surface of the substrate. These pins are the beginnings of mushroom primordia, which will develop into mature fruiting bodies. The time from full colonization to pinning is usually 5 to 10 days, but this can vary based on growing conditions.
To encourage pinning, growers often introduce a "fruiting trigger" after colonization. This involves reducing the temperature slightly, increasing air exchange, and providing indirect light. For example, lowering the temperature to around 60°F to 65°F (15°C to 18°C) and ensuring 12 hours of diffused light per day can stimulate pin formation. Misting the growing area lightly to maintain high humidity (around 85-95%) is also beneficial during this stage, as it mimics the natural environment where oyster mushrooms thrive.
In summary, the spawn to fruiting phase for oyster mushrooms generally spans 2 to 4 weeks, with pinning occurring 5 to 10 days after full colonization. Success during this period relies on precise control of temperature, humidity, and environmental conditions. By understanding and managing these factors, growers can optimize the timeline and ensure a healthy crop of oyster mushrooms. Patience and attention to detail are key, as even small adjustments can significantly impact the speed and quality of fruiting.
How Long Do Jarred Mushrooms Last After Opening?
You may want to see also

Fruiting Duration: How long mushrooms take to grow from pins to harvestable size
The fruiting duration of oyster mushrooms, from the appearance of pins to harvestable size, typically ranges from 5 to 14 days, depending on environmental conditions and cultivation practices. Pins, the tiny mushroom primordia, are the first visible signs of fruiting and emerge when the mycelium is ready to produce mushrooms. During this stage, maintaining optimal humidity (around 85-95%) and temperature (55-75°F or 13-24°C) is crucial to encourage rapid pin development. Proper airflow is also essential to prevent contamination and ensure even growth.
Once pins form, they begin to elongate and develop caps, a process that usually takes 3 to 7 days under ideal conditions. The growth rate accelerates as the mushrooms absorb moisture and nutrients from the substrate. During this phase, humidity should be slightly reduced to 80-85% to prevent waterlogging, while temperature can remain consistent. Light exposure, though not critical for oyster mushrooms, can stimulate cap expansion and improve overall fruiting body development.
The final stage of fruiting, from cap expansion to harvestable size, typically takes 2 to 5 days. Oyster mushrooms are best harvested when the caps are fully expanded but before the edges begin to curl upward and release spores. Overripe mushrooms may have a shorter shelf life and less desirable texture. Monitoring the fruiting bodies daily is essential to determine the optimal harvest time, as growth can be rapid during this period.
Environmental factors significantly influence the fruiting duration. Higher temperatures within the optimal range can expedite growth, while cooler temperatures may slow it down. Humidity levels must be carefully managed, as insufficient moisture can stunt growth, while excessive humidity can lead to mold or bacterial contamination. Additionally, the quality of the substrate and the health of the mycelium play pivotal roles in determining how quickly and efficiently mushrooms reach harvestable size.
For home growers, understanding and controlling these variables can help streamline the fruiting process. Using a humidifier, misting the mushrooms regularly, and maintaining a clean growing environment are practical steps to ensure a successful harvest. Commercial growers often employ more sophisticated techniques, such as climate-controlled grow rooms and automated misting systems, to optimize fruiting duration and yield. By closely monitoring the growth stages and adjusting conditions as needed, cultivators can consistently produce high-quality oyster mushrooms within the typical 5 to 14-day fruiting window.
Perfect Instant Pot Mushrooms: Quick Cooking Time Guide
You may want to see also

Environmental Factors: Impact of temperature, humidity, and light on growth speed
Oyster mushrooms (Pleurotus ostreatus) are relatively quick-growing fungi, but their growth speed is significantly influenced by environmental factors, particularly temperature, humidity, and light. Understanding these factors is crucial for optimizing cultivation and ensuring a successful harvest. Temperature plays a pivotal role in the growth cycle of oyster mushrooms. The ideal temperature range for their growth is between 65°F and 75°F (18°C and 24°C). At these temperatures, mycelium colonization and fruiting body formation occur most efficiently. If temperatures drop below 55°F (13°C), growth slows dramatically, and below 40°F (4°C), it may halt entirely. Conversely, temperatures above 80°F (27°C) can stress the mycelium, leading to reduced yields or even the death of the culture. Thus, maintaining a stable temperature within the optimal range is essential for maximizing growth speed.
Humidity is another critical factor affecting oyster mushroom growth. These mushrooms thrive in high-humidity environments, ideally between 70% and 90%. During the fruiting stage, adequate humidity ensures proper pinhead formation and prevents the mushrooms from drying out. Low humidity levels can stunt growth and result in deformed or underdeveloped fruiting bodies. To maintain optimal humidity, cultivators often use humidifiers or misting systems. Additionally, covering the growing substrate with a plastic dome or using a humidity tent can create a microclimate conducive to rapid growth. Monitoring humidity levels regularly and adjusting as needed is key to achieving the shortest possible growth cycle.
Light, while not as critical as temperature and humidity, still plays a role in oyster mushroom cultivation. Unlike plants, mushrooms do not require light for photosynthesis, but indirect light is necessary to trigger fruiting. A daily exposure of 8–12 hours of diffused natural or artificial light encourages the mycelium to produce fruiting bodies. Direct sunlight should be avoided, as it can dry out the substrate and harm the mushrooms. In indoor settings, fluorescent or LED grow lights can be used to provide the necessary light spectrum without generating excessive heat. Proper light management ensures that the mushrooms develop uniformly and reach maturity within the expected timeframe.
The interplay between temperature, humidity, and light is particularly important for accelerating growth. For instance, maintaining the ideal temperature range while ensuring high humidity and adequate light exposure can reduce the time from spawning to harvest to as little as 2–3 weeks. Conversely, suboptimal conditions can extend the growth period to 4–6 weeks or longer. Cultivators must carefully monitor and adjust these environmental factors to create a balanced ecosystem that promotes rapid and healthy mushroom development. By doing so, they can minimize the time required for oyster mushrooms to grow while maximizing yield and quality.
In summary, environmental factors such as temperature, humidity, and light have a profound impact on the growth speed of oyster mushrooms. Optimal temperature, high humidity, and proper light exposure are essential for achieving the shortest possible growth cycle. Cultivators must remain vigilant in managing these conditions to ensure consistent and efficient mushroom production. Whether growing oyster mushrooms at home or on a commercial scale, mastering these environmental factors is the key to success.
Perfectly Steamed Mushrooms: Timing Tips for Optimal Texture and Flavor
You may want to see also
Explore related products
$15.99 $19.99

Substrate Breakdown: Time needed for mycelium to colonize the growing substrate fully
The time required for mycelium to fully colonize the growing substrate is a critical phase in oyster mushroom cultivation, directly influencing the overall growth timeline. This process, known as substrate breakdown, involves the mycelium—the vegetative part of the fungus—spreading throughout the substrate material, breaking it down, and preparing it for fruiting. The duration of this stage can vary significantly depending on several factors, including the type of substrate, environmental conditions, and the specific strain of oyster mushroom being cultivated.
For oyster mushrooms, commonly grown substrates include straw, sawdust, coffee grounds, and agricultural waste. Straw, for instance, is a popular choice due to its availability and ease of colonization. Under optimal conditions—temperatures between 70°F and 75°F (21°C and 24°C) and proper moisture levels—mycelium can fully colonize straw in 2 to 4 weeks. Sawdust, being denser and more complex, typically takes longer, ranging from 4 to 6 weeks. Coffee grounds, rich in nutrients, may be colonized in 2 to 3 weeks, but their high moisture content requires careful management to prevent contamination.
Environmental factors play a pivotal role in substrate colonization. Temperature is particularly crucial; cooler temperatures slow down mycelial growth, while higher temperatures can stress the mycelium or encourage contamination. Humidity must also be maintained at around 60-70% to ensure the substrate remains moist but not waterlogged. Proper aeration is essential to prevent anaerobic conditions, which can hinder mycelial growth. Additionally, the substrate should be sterilized or pasteurized to eliminate competing microorganisms, ensuring the mycelium can colonize efficiently.
The strain of oyster mushroom also affects colonization time. Some strains are faster colonizers due to their genetic makeup, while others may take longer. For example, *Pleurotus ostreatus* (the common oyster mushroom) typically colonizes substrates within the aforementioned timeframes, but hybrid or specialty strains may deviate. Monitoring the colonization process is key; once the substrate is fully white with mycelium and no visible brown spots remain, it is ready for the fruiting stage.
In summary, substrate breakdown for oyster mushrooms generally takes 2 to 6 weeks, depending on the substrate type, environmental conditions, and mushroom strain. Straw and coffee grounds are faster, while sawdust and denser materials require more time. Maintaining optimal temperature, humidity, and substrate preparation are essential to ensure timely and successful colonization, setting the stage for a productive fruiting period.
Portabella Mushrooms Shelf Life: Refrigerator Storage Tips and Duration
You may want to see also

Harvest Cycles: Frequency and number of flushes possible per grow cycle
Oyster mushrooms are a popular choice for home growers due to their relatively quick growth and multiple harvest cycles. Understanding the harvest cycles is crucial for maximizing yield and ensuring a continuous supply of fresh mushrooms. Typically, oyster mushrooms can produce 2 to 4 flushes per grow cycle, with each flush occurring at intervals of 5 to 10 days, depending on environmental conditions and growing techniques. The first flush usually appears 2 to 3 weeks after the mycelium has fully colonized the substrate, with subsequent flushes following closely if conditions remain optimal.
The frequency of harvest cycles is heavily influenced by factors such as temperature, humidity, and air exchange. Ideal conditions for oyster mushrooms include temperatures between 60°F and 75°F (15°C and 24°C) and humidity levels around 60-70%. Proper air exchange is also essential to prevent carbon dioxide buildup, which can inhibit fruiting. Under these conditions, the first flush is often the most abundant, with subsequent flushes gradually decreasing in yield. However, with careful management, growers can still achieve productive second and third flushes.
After the initial harvest, it’s important to rehydrate the substrate and maintain optimal conditions to encourage the next flush. This can be done by lightly misting the growing area and ensuring proper ventilation. The time between flushes can vary, but with consistent care, a new flush can emerge within 7 to 10 days. Growers should monitor the substrate’s moisture levels and adjust as needed to avoid drying out, which can halt further fruiting.
The total number of flushes per grow cycle depends on the health of the mycelium and the quality of the substrate. Straw-based substrates, for example, may support fewer flushes compared to sawdust or coffee grounds. On average, a well-maintained grow cycle can yield 2 to 3 significant flushes, with a possible fourth if conditions remain ideal. After the final flush, the substrate can be composted or used as mulch, as the mycelium will have exhausted its nutrients.
For those aiming to extend the harvest cycle, techniques like soaking the substrate in water for 12-24 hours between flushes can rejuvenate the mycelium and encourage additional fruiting. However, this method is not always guaranteed and depends on the substrate’s condition. Overall, oyster mushrooms’ ability to produce multiple flushes makes them an efficient and rewarding crop for both novice and experienced growers. By understanding and optimizing harvest cycles, growers can enjoy a steady supply of mushrooms over several weeks.
Perfectly Cooked Stuffed Portabella Mushrooms: Timing Tips for Delicious Results
You may want to see also
Frequently asked questions
Oyster mushrooms typically take 2-4 weeks to grow from spawn to harvest, depending on environmental conditions like temperature, humidity, and substrate quality.
Oyster mushrooms grow best at temperatures between 65°F and 75°F (18°C and 24°C). Maintaining this range can help them grow faster and more efficiently.
Yes, maintaining high humidity (around 85-95%) and adequate ventilation can significantly speed up the growth of oyster mushrooms, often reducing the time to harvest.
Once oyster mushrooms begin pinning (forming small mushroom buds), they usually take 5-7 days to fully mature and be ready for harvest.